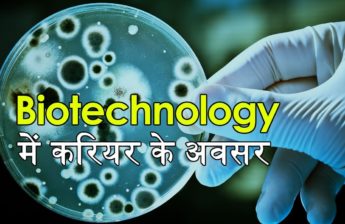
post-image

#AeronauticalEngineering #AerospaceEngineering #CareerOptions #After12th
12वी के बाद एरोनॉटिकल इंजीनियर । Aeronautical Engineer after 12th। News in Science
In This Video:
After finishing 12th class Board exams most of the students in India along with their parents got confused about what career they should choose. Generally, PCM and PCB are the subjects they opt in 12th but in the lack of information about their interest and subjects they choose wrong branches of career. So here we will solve your problems with our new segment of News in science in which we will let you know most of the interesting, technical and non-technical options of career.
What is Aeronautical Engineering?
If you like mathematics and you have completed your 12th class with PCB/PCM you can go for Aeronautical Engineering. Aeronautical Engineering is one of the most interesting career options where you can learn about spacecraft and aviation.
How to become an Aeronautical Engineer?
In this video, we will tell you all the important steps of how to become an Aeronautical Engineer. In this segment, we will tell you briefly about the best Aeronautical Engineering Colleges in India and also processes to apply in an exam.
Keeping this into mind recently CBSE board has launched a Guide Book for School students to choose their career after 12th. This Guide book covers about 1300 technical and non-technical coursed along with the university and colleges.
In this video we have covered topics:
1) How to become an Aeronautical Engineer?
2) How to do Aerospace Engineering?
3) Scope of Aeronautical Engineering in India.
4) List of Aeronautical Engineering Colleges in India.
5) Career options after 12th science.
6) How many years course in aeronautical engineering?
7) Which college is best for aeronautical engineering in India?
_______________________________________________________________________________________________
12वीं की परीक्षा पास करने के बाद अक्सर ही छात्रों और अभिभावकों के सामने करीयर चुनने की एक सबसे बड़ी समस्या आती है। पीसीएम और पीसीबी के साथ बारहवीं करने वाले बच्चे अक्सर सही जानकारी के अभाव में गलत करीयर का चुनाव कर लेते हैं ऐसे में न्यूज़ इन साइंस आपके लिए एक नया सेगमेंट करीयर लेकर आया है जहां हम आपको करीयर के सभी टेक्निकल और नॉनटेक्निकल कोर्सेज़ के बारे में बताएंगे।
अगर आपको मैथ्स पसंद है तो एरोनॉटिकल इंजीनियरिंग आपके लिए एक अच्छा ऑप्शन हो सकता है जहां स्पेसक्राफ्ट के बारे में जानकारी दी जाती है। इस वीडियो में हम आपको बताएंगे कि कैसे आप एक सफल एरोनॉटिकल इंजीनियर बन सकते हैं। हम आपको भारत में मौजूद एरोनॉटिकल इंजीनियर की सभी बेस्ट कॉलेज और साथ ही साथ टेस्ट प्रक्रिया की भी पूरी जानकारी देंगे